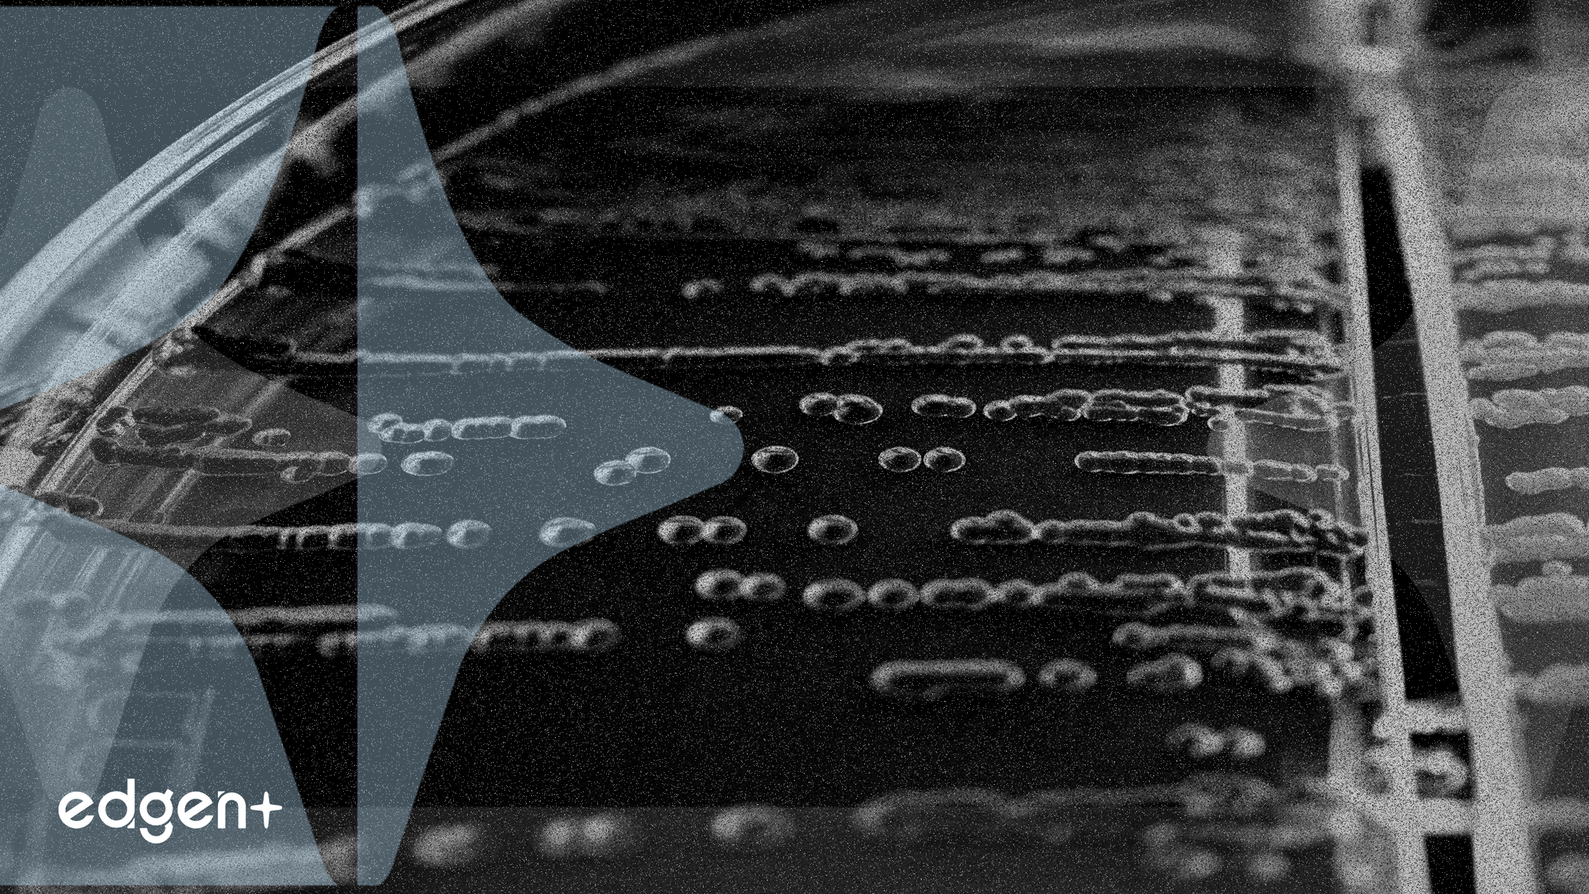
Thermo Fisher Boosts Biomanufacturing with New E. coli Media

source:[1] Neonatal bone marrow interstitial fluid supports expansion and osteogenic ability of human bone marrow mesenchymal stromal cells - Nature (https://www.nature.com/articles/s41413-025-00 ...)[2] Fermi Inc. (FRMI) Stock News Today: Shares Sink After $150M Project Matador Funding Deal Ends — Forecasts, Analyst Targets, and What’s Next (Dec. 14, 2025) - ts2.tech (https://ts2.tech/en/fermi-inc-frmi-stock-news ...)[3] A grad student’s wild idea triggers a major aging breakthrough - ScienceDaily (http://www.sciencedaily.com/releases/2025/12/ ...)